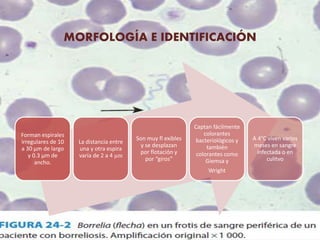
MORFOLOGÍA E IDENTIFICACIÓN
Forman espirales
irregulares de 10
a 30 μm de largo
y 0.3 μm de
ancho.
La distancia entre
una y otra espira
varía de 2 a 4 µm
Son muy fl exibles
y se desplazan
por flotación y
por “giros”
Captan fácilmente
colorantes
bacteriológicos y
también
colorantes como
Giemsa y
Wright
A 4°C viven varios
meses en sangre
infectada o en
culitvo

1) Las espiroquetas son bacterias gramnegativas, helicoidales y patógenas para el hombre que incluyen los géneros Treponema, Borrelia y Leptospira.
2) La sífilis es causada por Treponema pallidum e incluye etapas primarias, secundarias y latentes así como complicaciones tardías. Se transmite principalmente por contacto sexual.
3) La frambesia o mal del pinto es producida por Treponema carateum y se transmite por contacto directo con lesiones, presentando etap



































![FISIOLOGÍA Y
ESTRUCTURA
Se tiñen mal con los reactivos
de la tinción de Gram
No se los considera ni grampositivos ni
gramnegativos
Suelen ser más grandes que otras
espiroquetas (0,2 a 0,5 X 8 a 30 µm
Se tiñen bien con colorantes de anilinas
[p. ej., tinción de Giemsa o de Wright]
Se pueden observar mediante el
microscopio óptico cuando están
presentes en las extensiones de sangre
periférica de los pacientes con fiebre
recurrente
Poseen entre 7 y 20 flagelos
periplásmicos, que le permiten su
movilidad
Son microaerófilas y tienen unas
necesidades nutricionales exigentes](https://image.slidesharecdn.com/espiroquetas11-171121011345/85/Espiroquetas-36-320.jpg)

![BIBILIOGRAFIA
Ángela de Cadena, Fernando Botero, Walter León. Enfermedad de Lyme: Un caso comprobado en
Colombia. Diciembre, 2000. [Internet] .Tomado de
http://revistas.ces.edu.co/index.php/medicina/article/view/751/460
David Šmajs, Lenka Paštěková, y Linda Grillová. Macrolide Resistance in the Syphilis
Spirochete, Treponema pallidumssp. pallidum: Can We Also Expect Macrolide-Resistant Yaws
Strains?. ASTMH. 2015 Oct 7, [18 Oct 2017] Volumen 93. URL:
https://www.ncbi.nlm.nih.gov/pmc/articles/PMC4596581/
Lola V. Stamm. Program in Infectious Diseases, Department of Epidemiology, Gillings School of
Global Public Health, University of North Carolina, Chapel Hill, North Carolina. Global Challenge
of Antibiotic-Resistant Treponema pallidum.Journals. ASM.Org [Internet]. 5 Octubre 2009. [18
Oct 2017]. Volumen 54. URL: http://aac.asm.org/content/54/2/583.full#corresp-1
Mantilla Florez,Y. Faccini Martínez A, Perez-Díaz , C .American woman with early Lyme borreliosis
diagnosed in a Colombian hospital. Travel Medicine and Infectious Disease. Abril, 2017 [Internet].
Tomado de https://www.ncbi.nlm.nih.gov/pubmed/28153712
Murray R. Microbiología médica. España: S.A. ELSEVIER ESPAÑA,2013. 7° Edición
República de Colombia. Ministerio de la Protección Social. Guía de práctica clínica basada en la
evidencia para la atención integral de la sífilis gestacional y congénita [Internet]. 2015 jul 21, 19
Oct 2017. Disponible en: http://www.ins.gov.co/lineas-de-accion/Subdireccion-
Vigilancia/sivigila/Protocolos%20SIVIGILA/PRO%20Sifilis%20Gestacional%20y%20Congenita.pdf
Zotta, C. Gómez, D. Lavayén, S. Infecciones de transmisión sexual por Ureaplasma urealyticum y
Mycoplasma hominis. Sociedad Iberoamericana de Información Científica , Marzo, 2013
[Internet] Tomado de http://www.ine.gov.ar/documentos/publicaciones/028.pdf](https://image.slidesharecdn.com/espiroquetas11-171121011345/85/Espiroquetas-121-320.jpg)
![Rivera Tapia, J. Centeno Torres, M. Prevalencia de Ureaplasma urealyticum en mujeres.
Rev Mex Patol Clin. Marzo, 2004 [Internet]. Tomado de
http://www.medigraphic.com/pdfs/patol/pt-2004/pt041g.pdf
Rodríguez Pendás,B. Ortiz Rodríguez, Santana Pérez, F. Micoplasma
hominis, Ureaplasma urealyticum y bacterias aeróbicas en el semen de hombres que
consultan por infertilidad. Rev Cubana Endocrinol. Abril, 2013. [Internet] Tomado de
http://scielo.sld.cu/scielo.php?script=sci_arttext&pid=S1561-29532013000100005](https://image.slidesharecdn.com/espiroquetas11-171121011345/85/Espiroquetas-122-320.jpg)